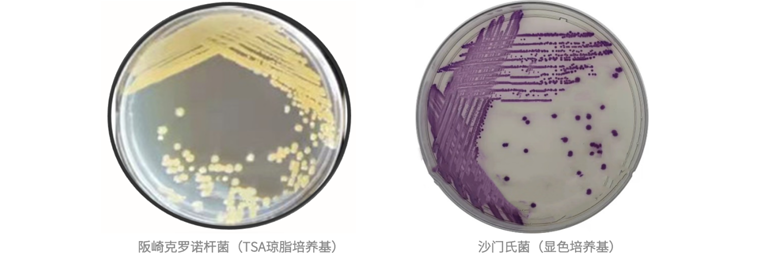

会员动态
某知名品牌婴幼儿奶粉召回,MALDI-TOF快速鉴定致病菌
导读
据人民网消息,海关总署2月20日发布公告,提醒消费者暂不通过任何渠道购买和食用某国际著名品牌旗下相关婴幼儿产品,包括多款婴幼儿奶粉。公告中提到了美国FDA正在调查该品牌婴幼儿感染阪崎克洛诺杆菌及沙门氏菌的事件。该类产品已销往中国、印度、加拿大等30多个国家和地区,相关企业已启动自主召回涉及的婴幼儿产品。国际主流媒体均在第一时间报道了此次奶粉召回事件,并着重强调了相关致病菌对婴幼儿健康的危害。回首过往,婴幼儿奶粉中的非法添加物和食源性致病菌事件也经常发生。本次婴幼儿奶粉感染致病菌事件,再次牵动公众神经。
认识阪崎克罗诺杆菌和沙门氏菌
阪崎克罗诺杆菌(Cronobacter sakazakii)原为阪崎肠杆菌(Enterobacter sakazakii),隶属于肠杆菌科,革兰氏阴性无芽孢杆菌。2008年Iversen等人通过16S rRNA基因测序等分子生物学技术研究确认,将该菌命名为阪崎克洛诺杆菌。阪崎克罗诺杆菌主要在奶粉(乳)制品中被发现,可通过污染婴幼儿配方奶粉等食品导致脑膜炎、菌血症和坏死性小肠结炎等,例如本次事件造成了四名患儿中一名婴儿死亡。据联合国粮农组织和世卫组织合编的《安全制备、贮存和操作婴儿配方奶粉指导原则》,应使用温度不低于70℃的温水来冲调婴儿配方奶粉,以杀死奶粉中的阪崎肠杆菌。
沙门氏菌(Salmonella)是一种肠道致病菌,属肠杆菌科,革兰氏阴性肠道杆菌。不同类型的沙门氏菌可引发伤害、副伤寒、发热、腹痛等症状。沙门氏菌的最佳繁殖温度为37℃,高于20℃即可大量繁殖,因此食品在冰箱中低温储存是避免沙门氏菌感染的有效预防措施。
奶粉中微生物检测相关标准
国内最早关于奶粉中阪崎克罗诺杆菌(阪崎肠杆菌)检测的行业标准,是2005年10月由中国检验检疫科学研究院和天津出入境检验检疫局(天津海关)牵头完成的《奶粉中阪崎肠杆菌检测方法》,填补了国内婴幼儿配方奶粉中阪崎克罗诺杆菌相关检测标准与方法的空白。
现行的国家标准《GB 10765-2010 食品安全国家标准 婴儿配方食品》,规定6个月以下的婴幼儿奶粉中,食源性致病菌阪崎克罗诺杆菌和沙门氏菌要求零检出。
婴儿配方食品国家标准及对微生物检测的要求
MALDI-TOF快速检测奶粉中致病菌
微生物鉴定的传统方法有形态学观测、实时荧光PCR法、16S rRNA基因测序法、生化反应法、免疫学方法等,但耗时都比较长,试剂耗材成本较高。近几年兴起的基质辅助激光解吸电离飞行时间质谱法(MALDI-TOF),微生物培养好后几分钟即可给出鉴定结果,比传统方法速度更快,成本更低,通量更高。
●岛津MALDI-TOF iDPlus 微生物快速鉴定系统
该鉴定系统工作流程主要由微生物样品培养前处理、质谱数据采集和SARAMIS数据库鉴定三个阶段组成。
MALDI-TOF微生物鉴定流程图
●阪崎克罗诺杆菌和沙门氏菌鉴定
阪崎克罗诺杆菌质谱图及鉴定结果
沙门氏菌质谱图及鉴定结果
●用户心声
针对婴幼儿奶粉中致病菌阪崎克罗诺杆菌及沙门氏菌的鉴定,天津海关动植物与食品检测中心有着多年的检测经验。该中心赵宏博士表示MALDI-TOF质谱法已越来越普遍地应用于食源性致病菌的检测,同时与传统生化反应及基因测序等方法相比,结果之间的匹配度也非常高。MALDI-TOF质谱法的优势在于前处理简单,检测时间更短,通量更高,日常使用所需试剂耗材成本更低,目前已在医院检验科、疾控中心、海关技术中心、科研院所等单位广泛使用。
赵宏博士做奶粉中致病菌检测讲座
结语
对于食源性致病菌的鉴定,MALDI-TOF质谱法具有准确度高、特异性好、速度快、高通量、低成本等优势,鉴定过程耗时只需数分钟,适用于大规模菌株的准确鉴定。使用岛津MALDI-TOF iDPlus 微生物鉴定系统,结合SARAMIS数据库,可以快速高效的进行奶粉中阪崎克罗诺杆菌、沙门氏菌等的快速检测,守护婴幼儿舌尖上的安全。
本文内容非商业广告,仅供专业人士参考。